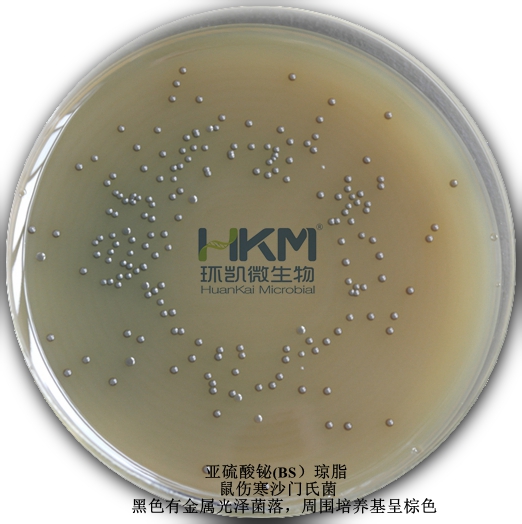
鼠伤寒沙门氏菌

沙门氏菌检测标准、方法及实验关键点
发布时间:2025-05-09 浏览次数:15267
来源:“食品微生物检验”公众号
原文标题:《沙门氏菌检测标准、方法及实验关键点》
一、检验沙门氏菌的原因和意义:
据统计我国细菌性食物中毒中70%~80%是由沙门氏菌引起的,人一旦摄入含有大量沙门氏菌(105~(106个/g)的动物性产品,就会引起细菌性感染,进而在毒素作用下发生食物中毒导致胃肠炎、伤寒和副伤寒且沙门氏菌的传播媒介众多,肉、蛋以及食品从加工到出售的过程中都十分容易发生污染。因此对沙门氏菌的检验事关重大。

二、检测及鉴定:
沙门氏菌的检测要在二级生物安全实验室及二级生物安全柜(在负压情况下防止致病微生物气溶胶飘离实验室对实验人员及环境造成污染)中进行。
限值要求:参考CAC、ICMSF、欧盟、澳大利亚和新西兰、美国、加拿大、香港、台湾等国际组织、国家和地区的即食食品中沙门氏菌限量标准及规定,《GB 29921-2021食品中致病菌限量》按照二级采样方案对乳制品、肉制品、水产制品、即食蛋制品、粮食制品、即食豆类制品、巧克力类及可可制品、即食果蔬制品、饮料、冷冻饮品、即食调味品、坚果与籽类食品和特殊膳食用食品13类食品设置了沙门氏菌限量规定,即n=5,c=0,m=0(指在被检的5份样品中,不允许任一样品检出该菌)。
检测方法:目前常用的沙门氏菌的检测方法标准为《GB 4789.4-2016 食品安全国家标准 食品微生物学检验 沙门氏菌检验》,该标准以微生物培养的方式可对样品进行定性检测,检测周期一般为6-7天。
三、沙门氏菌传统检测方法的关键控制点
1、样品处理:尽可能缩短解冻时间,使竟争菌群生长最少,并减小对沙门氏菌的损伤致病菌取样一定要均匀并具有代表性(蛋黄蛋清混匀取样)。
2、培养基及培养方面
1)没有一种培养基可疑准确无误的筛选出沙门氏菌,必须选择多种选择性培养基同时筛选,只能说显色培养基综合选择性更强。
2)试剂和培养基的配置一定要严格按照说明书配置,是否需要高压灭菌,添加剂用量及培养基保存条件。
3)有1%沙门氏菌乳糖发酵阳性,为了避免漏检乳糖阳性菌必须选择不依赖乳糖的培养基,目前BS培养基认为是最适合的。
4)BS培养基是分离沙门氏菌的高效培养基,特别适用于伤寒类的沙门氏菌,不是所有的选择性培养基都能有效分离出伤寒沙门氏菌和副伤寒沙门氏菌,BS是分离伤寒类沙门氏菌的首选培养基。
5)BS不能高压,不能过热溶解,只能在使用前一天配置,保存在阴暗处,48h后失去选择性,保存不当,颜色变浅标明已经开始减效。
6)HE不能高压灭菌,煮沸不能超过1min,水域中冷却,只能保存一天;XLD平板不能高压,不能过热煮沸,保存一天。
7)TTB的添加剂必须在棕色瓶储存,不能见光,否则选择性减弱。TTB有碳酸钙沉淀,分装时一定要摇匀,碳酸钙作用是消除和吸收有毒代谢产物。TTB加入添加剂后就不能再加热。
8)SC种含有亚硒酸氢钠,剧毒物质,使用时候要注意安全,当天使用当天配置。
9)TSI要制备成高柱斜面,有助于结果判读。
10)TSI和赖氨酸脱羧酶可以筛选掉大部分非沙门氏菌。
11)典型沙门菌培养基,斜面显红色,底端显黄色,有气体产生,有90%形成硫化氢,琼脂变黑。当分离到乳糖阳性沙门菌时,三糖铁斜面是黄色的,因而要确认沙门菌,不应仅仅限于三糖铁培养的结果。
12)标准要求的培养时间要按最长时间培养,否则会漏检风险。
13)从挑选可疑菌落开始,建议每步都同时划线营养琼脂平板,确保每个菌落均为纯菌。
3、生化反应
1)生化反应要用纯菌落进行(从营养琼脂中挑取单个菌落制备成适宜浓度的菌悬液)。
2)多种生化试验同时测试可以提高检测效率。
4、血清学鉴定

1)血清学鉴定是沙门氏菌检验中的重要鉴定方法,包括菌体抗原(O)鉴定、鞭毛抗原(H)鉴定和Vi抗原鉴定。
2)只需要鉴定某个菌株是否属于沙门氏菌,那只需要做O多价和H多价血清就可以(大多数食源性沙门氏菌凝集A-F群O多价)。
3)判定时应该以生化试验结果为主,在生化试验的基础上进行血清学判定,血清学的原理是抗原抗体结合,非沙门氏菌的微生物也有可能带有沙门的类似抗原的。不可以不做生化只用血清初筛。
4)血清检测要使用24h内的纯菌,在规定时间内观察结果,并做自凝实验。
5)O血清不凝集时,将菌株接种在琼脂量较高的(如2.5%~3%)培养基上再检查;如果是由于VI抗原的存在而阻止了O凝集反应时,可挑取菌苔于1mL生理盐水中做成浓菌液,于酒精灯火焰上煮沸后再检查。H抗原发育不良时,将菌株接在0.55%~0.65%半固体琼脂平板的中央,侠菌落蔓延生长时,在其边缘部分取菌检查;或将菌株通过装有0.3%~0.4%半固体琼脂的小玻管1-2次,自远端取菌培养后再检查。
6)凝集不好的放室温(不要放冰箱)室温放置1-2天或者传代一次,可能凝集的要好些。
7)如果实验室条件许可建议购置进口血清,进口血清一般以泰国和丹麦血清为佳,国产和进口血清在判读时会有差异。
8)若实验室只有国产血清,可以同时使用两种厂家产品互相验证。
实验记录及结果报告
1、检测原始记录要求
1)样品信息全面(特殊样品状态描述)
2)检测方法信息全面(涉及第几法要标注)
3)实验环境温湿度
4)培养基培养温度、时间、批号
5)溯源性(能简单还原测试过程)
6)测试/审核人员签字
2、结果报告
1)报告阳性结果:检出沙门氏菌/25g 或mL
2)报告阴性结果:未检出沙门氏菌/25g 或mL
3)必要时将菌株送至专业检验检疫部门做进一步的血清学鉴定
3、实验室质量控制
1)不同方法/仪器间比对
2)过程中阳性/空白对照
3)实验室内部质量控制
4)实验室外部比对试验
说明:转载仅为分享目的,部分文章图片因转载众多无法确认原始作者的,仅标明转载来源;版权归原作者所有,如有问题,请联系小编删除,谢谢!
